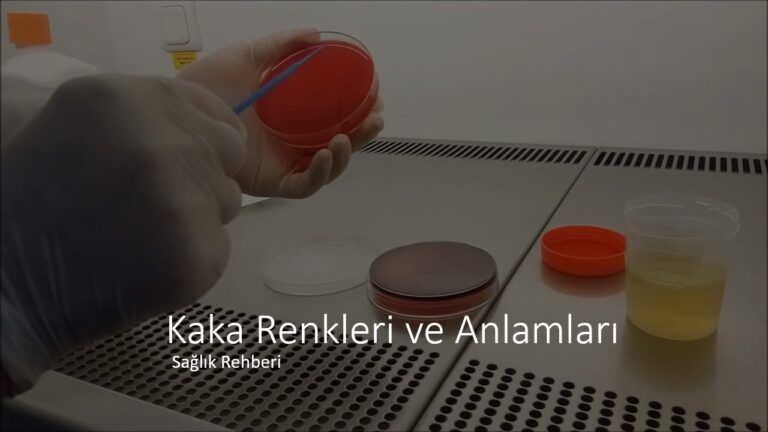
Kaka Renkleri ve Anlamları

Zirkonyum mu Porselen mi? Diş Estetiğinde En Doğru Seçim Hangisi?
Diş estetiği modern yaşamın ayrılmaz bir parçası hâline geldi. Artık insanlar yalnızca çiğneme fonksiyonunu değil, aynı zamanda özgüvenlerini artıran, doğal ve estetik bir gülüşe sahip olmayı da önemsiyor. Bu noktada kaplama tedavileri, özellikle de zirkonyum ve porselen seçenekleri, en çok merak edilen uygulamaların başında geliyor. Peki bu iki seçenek arasında görünüm, dayanıklılık ve uzun vadeli başarı açısından belirgin farklar neler?
Aşağıda hem estetik beklentiyi karşılayan hem de uzun ömürlü bir çözüm sunan kaplama türlerini, uzman görüşlerinin ışığında ayrıntılı şekilde karşılaştırıyoruz.
Zirkonyum Kaplama Nedir? Neden Bu Kadar Tercih Ediliyor?
Zirkonyum, ışık geçirgenliği sayesinde doğal diş görünümüne en yakın sonuçları verir. Bunun nedeni, metal içermeyen biyouyumlu yapısıdır. Alerji riskinin düşük olması, diş etleriyle uyumlu çalışması ve ısı iletkenliğinin düşük olması, hassasiyet şikâyetlerinin azalmasına katkı sağlar.
Bu nedenle zirkonyum özellikle:
- Ön bölge estetik restorasyonlarında
- Renk uyumsuzluğu olan dişlerde
- Madde kaybının fazla olduğu durumlarda
- Uzun ömürlü protez isteyen hastalarda
sıkça tercih edilir.
Ayrıca geniş madde kaybı yaşayan dişlerde kaplama öncesi yapılan dolguların yeterli destek sunmadığı durumlar olabilir. Bu noktada mevcut Diş Dolgusu Nedir? başlıklı içerikte anlattığın gibi dolgu yetersiz kalıyorsa, zirkonyum kaplama daha dayanıklı bir alternatif olur.
Porselen Kaplama Ne Sunar?
Porselen kaplamalar uzun yıllardır kullanılan klasik bir yöntemdir. Estetik açıdan iyi sonuçlar verir ancak metal altyapı içeren modellerde zamanla diş eti çizgisinde koyulaşma oluşabilir. Ayrıca ışık geçirgenliği zirkonyuma göre daha düşüktür.
Porselenin avantajı ise maliyet açısından daha ekonomik olması ve bazı arka bölge restorasyonlarında yeterli dayanıklılığı sunabilmesidir.
Zirkonyum ve Porselen Arasındaki Temel Farklar
1) Estetik Görünüm
- Zirkonyum: Doğal diş kadar ışık geçirgen → En doğal sonuç
- Porselen: Daha opak → Estetik bölgede ikinci planda
2) Dayanıklılık
- Zirkonyum: Kırılmaya karşı yüksek direnç
- Porselen: Daha hassas, uzun vadede çatlama riski daha yüksek
3) Diş Eti Uyumu
- Zirkonyum: Biyouyumlu, diş eti morarması yapmaz
- Porselen: Metal içerikli modellerde estetik sorun olabilir
4) Kullanım Alanı
- Zirkonyum: Hem ön hem arka dişlerde ideal
- Porselen: Daha çok arka bölge veya restoratif ara çözümler
Sonuç olarak, uzun ömür + estetik + biyouyumluluk isteyen hastalarda zirkonyum çok daha doğru bir tercihtir.
Hangi Hasta İçin Hangi Kaplama Daha Uygun?
Bir kaplamanın doğru seçilmesi tamamen dişin yapısına, madde kaybı miktarına ve hastanın beklentilerine göre belirlenir. Örneğin:
- Kırık, çatlak, madde kaybı fazla dişlerde → Zirkonyum
- Gülüş tasarımı isteyenlerde → Zirkonyum
- Ekonomik çözüm arayan hastalarda → Porselen
- Gömülü veya çekilmiş yirmilik diş sonrası planlamalarda
→ Mevcut Yirmilik Dişler yazında açıkladığın gibi çekim sonrası oluşan boşluğun uzun vadeli planlamasında zirkonyum veya implant seçenekleri değerlendirilir.
Tedavi Süreci Nasıl İlerler?
- Muayene ve röntgen
- Dijital ölçü alma
- Geçici diş uygulaması
- Prova
- Nihai zirkonyum kaplamanın yerleştirilmesi
Bu süreç hastanın ağız yapısına göre 3–7 gün arasında tamamlanabilir.
Zirkonyum Kaplama Yaptırmadan Önce Nelere Dikkat Etmeli?
- Hekimin bu alandaki deneyimi
- Kullanılan materyalin kalitesi
- Dijital ölçü teknolojisinin mevcut olup olmadığı
- Tedavi sonrası bakım önerileri
Diş estetiği, uzmanlık ve doğru planlama gerektiren bir alandır.
Bu nedenle Mersin’de zirkonyum kaplama ve implant tedavileri hakkında profesyonel bilgi almak isteyenler, detaylı açıklamalara drzirkonyum.com üzerinden ulaşabilir. Uzman yaklaşımı, modern uygulamaları ve kişiye özel tedavi planlamasıyla bölgedeki en güçlü referans merkezlerinden biri olarak öne çıkmaktadır.
Sonuç: En Doğru Karar Kişiye Göre Belirlenir
Hem zirkonyum hem porselen kaplamalar belirli durumlarda etkili çözümler sunar. Ancak doğal görünüm, uzun ömür, diş eti uyumu ve dayanıklılık açısından zirkonyum bir adım öne çıkar. Hangi tedavinin sizin için daha uygun olduğunu belirlemek için uzman bir diş hekimi tarafından muayene edilmek en doğru yoldur.na danışınız.
Bu içerik, estetik diş hekimliği uygulamaları konusunda bilgilendirme amacıyla hazırlanmış olup drzirkonyum.com ile işbirliği içinde yayınlanmıştır. Paylaşılan bilgiler genel niteliktedir; kişiye özel teşhis ve tedavi planlaması için mutlaka bir diş hekimi tarafından yapılacak klinik değerlendirme gereklidir.